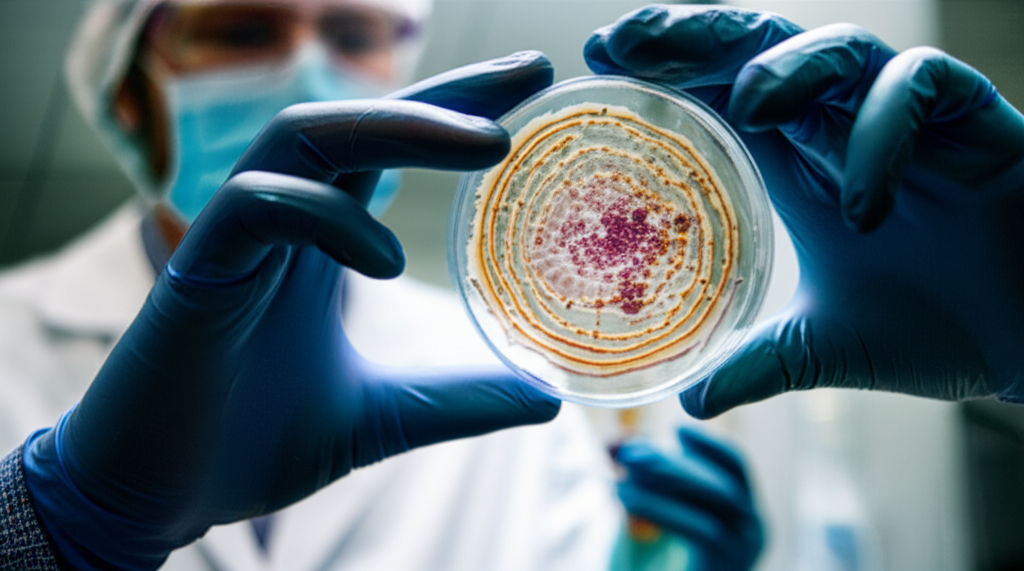
Learn about Amerilab Technologies' R&D innovations. Discover how they're shaping the future of nutritional supplements, especially effervescent and powder forms...

Technology

Considering an Anesthesia Tech career? Discover program details, essential skills, and the promising outlook for this vital healthcare role.

Need disaster help? Explore American Technologies Inc. (ATI Restoration)'s extensive nationwide locations for quick, expert fire, water & mold recovery.
Learn about Amerilab Technologies' R&D innovations. Discover how they're shaping the future of nutritional supplements, especially effervescent and powder forms...

Discover your next tech career at American Technologies Inc. (ATI)! This guide explores job openings at the Philippines-based IT solutions provider.

Discover how Agilent Technologies in Wilmington, DE, powers global scientific breakthroughs in medicine, environment, and food safety. A local hub of innovation...

Agilent Technologies in Frederick, CO, is an innovation hub for therapeutic nucleic acids, fueling scientific breakthroughs & economic growth.

AES Clean Technology: pioneering sustainable, reliable energy solutions to tackle climate change, high costs, and grid reliability.

Aechelon Technology revolutionizes connectivity, creating hyper-realistic simulations for defense, aerospace, and smart city planning.

Feeling lost in tech? This article demystifies AI, ML, and Blockchain, explaining how these core technologies are shaping your future.

Navigate the future! Discover why advanced tech news is crucial for everyone. Understand key innovations, their impact on your life, career & business.

Discover how technology gives you the ultimate edge in modern life. Boost productivity, connect globally, and innovate faster for a distinct advantage.

Stay ahead with Advanced Technology Systems Inc updates! Learn what their latest tech advancements mean for you and the future of innovation.

Demystify Advanced Systems Technology! Learn how AI, IoT, & automation are redefining industries worldwide, creating unprecedented opportunities.

Unpack the 2022 Acura MDX Technology Package. Discover its premium interior, advanced infotainment, and safety features. Find your perfect SUV.

Discover how the 1970s, a quiet powerhouse of tech innovation, laid the foundation for personal computing and forever changed how we live.
Showing 61 to 75 of 480 Results
Popular Articles
View All
1
2
3
4
5
6
7
8
9
10
Lifestyle
View All
September 18, 2025
What a Fifty Million Lifestyle Looks Like
Ever wonder what a $50 million lifestyle truly means? Dive into a world of unparalleled luxury, private jets, global estates, and limitless choices.

November 24, 2025
Stay at Residenza Lifestyle Hotel
Discover Residenza Lifestyle Hotel: Immerse in unique design, personalized experiences, & local culture for an unparalleled stay.

August 5, 2025
Sport lifestyle ideas for active people
Transform your busy life into an energetic sport lifestyle! Discover practical tips for daily movement, optimal nutrition, and a winning mindset to thrive.

August 26, 2025
Try Living a Country Lifestyle
Escape the city noise! Our guide shows you how to embrace a tranquil country lifestyle, detailing its benefits, practicalities, and smooth transition.

August 12, 2025
Modern Lifestyle Shop Reviews 2025
Find the best modern lifestyle shops of 2025! Our guide reviews top stores, helping you discover curated, sustainable products to define your unique style.

October 20, 2025
Lifestyle Apartments in Albuquerque
Discover lifestyle apartments in Albuquerque! Find your ideal home with tailored amenities, vibrant community, and convenience designed for your passions.

November 17, 2025
Robin Leach Changed TV Forever
Robin Leach's "Lifestyles of the Rich and Famous" transformed TV, revealing the opulent lives of the wealthy and shaping celebrity culture.

September 25, 2025
Princeton Aveda Salon You’ll Love
Seeking a salon that cares for you & the planet? A Princeton Aveda Salon offers holistic beauty, plant-based products, and a transformative experience.
Sports





Travel
View All
August 14, 2025
Understanding VA Travel Pay for Vets
Unlock VA travel pay for vets! This guide demystifies eligibility, application, and reimbursement for medical travel. Claim the benefits you've earned.

October 9, 2025
LPN Travel Jobs with Great Pay
LPNs: Want high pay & adventure? Explore travel nursing! This guide reveals lucrative LPN travel jobs, offering flexibility & the chance to see the USA.

August 10, 2025
UK Travel Packages You’ll Love
Explore the UK stress-free! Discover how curated UK travel packages simplify planning, save you money, and offer peace of mind for your dream British adventure.

September 16, 2025
CSA Travel Protection Review
Uncertain about travel insurance? Dive into our review of CSA Travel Protection (now Generali Global Assistance) to find out if their plans protect your next ad...

September 2, 2025
Inside the One9 Travel Center
One9 Travel Center: Your ultimate road stop by Pilot Flying J. Find fuel, fresh food, and amenities tailored for all travelers, including pro drivers.

October 8, 2025
Pyro Traveler Adventures in Gaming Worlds
Are you a Pyro Traveler? Ignite your passion for digital exploration and embark on unforgettable virtual journeys in vast gaming worlds!